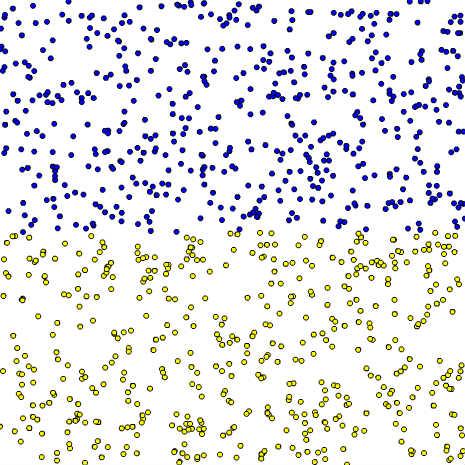

if文⑥
forked from 左右で円の色を変える (diff: 5)
ActionScript3 source code
/**
* Copyright N.YUUKI ( http://wonderfl.net/user/N.YUUKI )
* MIT License ( http://www.opensource.org/licenses/mit-license.php )
* Downloaded from: http://wonderfl.net/c/aop8
*/
// forked from shmdmoto's 左右で円の色を変える
package
{
import frocessing.display.F5MovieClip2D;
/**
* 円を左半分は赤色に右半分は青色にランダムに配置する
* @author shmdmoto
*/
public class GraphicExample extends F5MovieClip2D
{
public function setup() : void
{
var i:int;
var x:Number;
var y:Number;
for( i = 1 ; i <=1000 ; i++ ) {
x = random( 465 );
y = random( 465 );
if( y < 465 / 2) {
fill(0,0,255);
} else {
fill(255, 255, 0);
}
ellipse( x, y, 30, 30);
}
}
}
}